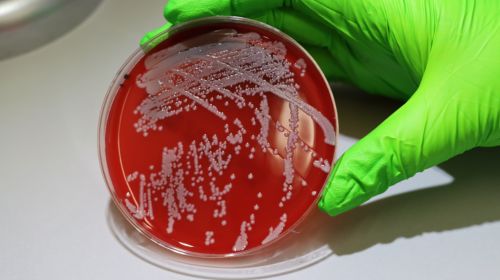

Abrir en el navegador
Abrir en el navegador
|

|

|
AseBio Te cuenta
|

|
El sector biotecnológico requiere ajustar la formación académica a las necesidades empresariales
AseBio ha presentado este martes el estudio “Perfiles profesionales en el sector biotech”, elaborado junto con la Plataforma...
Continuar leyendo
|
|

|

|
TerminAI, un proyecto innovador para optimizar la gestión de datos sanitarios mediante inteligencia artificial
Basque Health Cluster (BHC), tras haberse certificado como Asociación Empresarial Innovadora (AEI) en diciembre de 2023, ha...
Continuar leyendo
|
|

|
Bioga Comunica
|

|
Xornada da Industria: Innovación e talento global no corazón da Maker Faire Galicia
Santiago de Compostela será el escenario de la X Jornada de la Industria de Maker Faire Galicia, que se celebrará el próximo...
Continuar leyendo
|
|

|
Actualidad de Farmabiotec
|

|
Labiana lidera BME Growth en 2024 con una revalorización anual del 136,80% y la entrada de un inversor estratégico
Labiana, ha incorporado a Héctor Ara, a través de su family office Ancesmei, como accionista con un 5,01% del capital social....
Continuar leyendo
|
|

|

|
La Fundación Michael J. Fox financia un proyecto innovador liderado por Grifols para frenar la progresión de la enfermedad de Parkinson
Grifols, líder global en el sector salud y en la producción de medicamentos plasmáticos, ha recibido una subvención...
Continuar leyendo
|
|

|
Un estudio del CSIC desvela cómo se adapta Staphylococcus aureus en humanos, abriendo vías para nuevas terapias
El Instituto de Biomedicina de Valencia (IBV), del Consejo Superior de Investigaciones Científicas (CSIC), ha liderado un estudio...
Continuar leyendo
|
|

|

|
Cube Biotech e IBA Lifesciences se fusionan para revolucionar la investigación en ciencias de la vida
Cube Biotech e IBA Lifesciences, dos referentes en la industria biotecnológica, han anunciado su fusión para crear una entidad...
Continuar leyendo
|
|

|
Oryzon Genomics, líder español en intensidad de inversión en I+D según el ranking de la UE
Oryzon Genomics S.A., compañía biofarmacéutica especializada en epigenética, se ha posicionado entre las 800...
Continuar leyendo
|
|

|

|
El Sistema Nacional de Salud incorpora pruebas farmacogenómicas para impulsar la Medicina Personalizada de Precisión
El Consejo Interterritorial del Sistema Nacional de Salud aprobó el pasado 23 de junio de 2023 un catálogo de pruebas genéticas,...
Continuar leyendo
|
|

|
Nueva tecnología MEMP: pulsos electromagnéticos no invasivos para tratar el cáncer
Los Pulsos Electromagnéticos Multifrecuencia No Ionizantes (MEMP), desarrollados por Paso Alto Group Inc., representan una novedosa...
Continuar leyendo
|
|

|

|
Nuevo convenio entre Farmaindustria y Biocat refuerza la colaboración público-privada en terapias avanzadas y medicina personalizada
La Asociación Nacional Empresarial de la Industria Farmacéutica (Farmaindustria) y Biocat han firmado un convenio de colaboración...
Continuar leyendo
|
|

|
Nuevas evidencias de terapias CAR-T muestran avances en tumores hematológicos y enfermedades autoinmunes
Bristol Myers Squibb ha presentado resultados destacados en el 66º Congreso de la Sociedad Americana de Hematología (ASH),...
Continuar leyendo
|
|

|

|
Descubren mecanismos genéticos compartidos entre la COVID-19 grave y la fibrosis pulmonar idiopática
Un equipo internacional liderado por el Centro de Investigación Biomédica en Red (CIBER) ha descubierto mecanismos biológicos...
Continuar leyendo
|
|

|
Hifas da Terra lidera la investigación biotecnológica en el proyecto AI-VIDDA para frenar el deterioro cognitivo
Hifas da Terra se posiciona a la vanguardia de la biotecnología al formar parte del proyecto AI-VIDDA, una iniciativa innovadora...
Continuar leyendo
|
|

|

|
La AEMPS aprueba por primera vez un ensayo clínico en fase I a través del procedimiento fast-track.
La Agencia Española de Medicamentos y Productos Sanitarios (AEMPS) ha aprobado su primer procedimiento de evaluación acelerada...
Continuar leyendo
|
|

|
Identifican un mecanismo genético clave en el desarrollo craneofacial humano
Un equipo internacional coliderado por el Instituto de Neurociencias (IN), centro mixto del CSIC y la Universidad Miguel Hernández...
Continuar leyendo
|
|

|

|
El Gobierno presenta la Estrategia de la Industria Farmacéutica 2024-2028
El Ministerio de Sanidad ha anunciado el lanzamiento de la Estrategia de la Industria Farmacéutica 2024-2028, un plan que busca fortalecer...
Continuar leyendo
|
|

|
El Centro de Ciencias Ómicas refuerza su liderazgo con dos espectrómetros de masas de última generación
El Centro de Ciencias Ómicas (COS), una unidad mixta de la Universitat Rovira i Virgili y el centro tecnológico Eurecat, ha...
Continuar leyendo
|
|

|

|
El CSIC obtiene cinco ayudas ERC Consolidator Grants para proyectos científicos pioneros
Cinco proyectos liderados por investigadores del Consejo Superior de Investigaciones Científicas (CSIC) han sido seleccionados para...
Continuar leyendo
|
|

|
Resultados prometedores: terapia génica sin quimioterapia muestra eficacia en la anemia de Fanconi
Un ensayo clínico español ha demostrado que la terapia génica puede ser eficaz y segura en pacientes con anemia de...
Continuar leyendo
|
|

|

|

|
Artículos
|

|
Redefiniendo el estudio del genoma: long-read sequencing
El descubrimiento de Fred Sanger revolucionó la biología molecular al proporcionar una forma de determinar el orden exacto de los nucleótidos...
Artículo completo
|
|

|

|
Modelos hepáticos en 3 dimensiones: el futuro para el cribado de fármacos en fases preclínicas
Solo 1 de cada 10 fármacos que entran en fase de ensayos clínicos logra obtener la aprobación regulatoria. La industria farmacéutica...
Artículo completo
|
|

|
Factores Claves para Escoger la CDMO Adecuada para la Producción de Vacunas
El desarrollo de vacunas ha ganado una gran relevancia en los últimos años, especialmente a raíz de las pandemias globales. En este contexto,...
Artículo completo
|
|

|
Eventos recomendados
|

|
Medicalforum
20/05/2025
Tlf. +34 91 630 85 91 / +34 672 050 625 - Mail comercial@medicalforum.es, Barcelona (España)
Más información
|
|

|
Farmaforum 2025
17/09/2025
IFEMA, Pabellón 9, Madrid (España)
Más información
|
|
Empresas premium
|

|
|
Este mensaje y sus adjuntos contienen información confidencial y reservada dirigida exclusivamente a su destinatario. Si ha recibido este mensaje por error, se ruega lo notifique inmediatamente por esta misma vía y borre el mensaje de su sistema. Nótese que el correo electrónico vía Internet no permite asegurar ni la confidencialidad de los mensajes que se transmiten ni la correcta recepción de los mismos. Los datos derivados de su correspondencia se incluyen en un fichero de titularidad de OMNIMEDIA, S.L. cuya finalidad exclusiva es gestionar las comunicaciones de la empresa entendiéndose que usted consiente el tratamiento de los mismos con dicha finalidad al mantener tal correspondencia. El ejercicio de sus derechos de acceso, rectificación, cancelación u oposición puede realizarlo dirigiéndose por escrito a la dirección C/ Pollensa, 2, Edif. Artemisa of. 12 de LA ROZAS (28290 - MADRID) adjuntando una fotocopia de su NIF o documento identificativo.
Este mensaje se ha enviado a {{ campaign.sender.email }} que está registrado dentro del listado de suscriptores de nuestra revista. Si no desea recibir más información y darse de baja de nuestros boletines click aquí
|